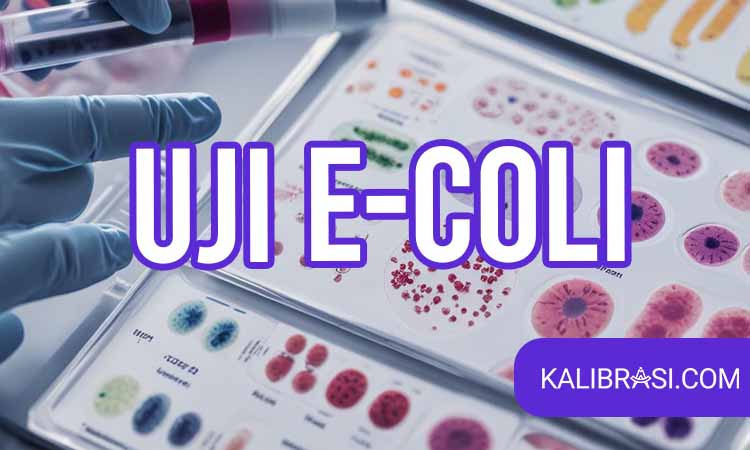
uji e. coli

Uji E. Coli merupakan metode yang dianjurkan oleh para ahli untuk dilakukan pada ekosistem air yang diduga terkontaminasi oleh bakteri E.coli. Selain metode yang digunakan pada pengujian ini terbilang praktis, namun langkah uji E. Coli dinilai efektif untuk keberlangsungan air bersih.
Namun sebelum Anda dapat melakukan pengujian bakteri E.coli menggunakan metode ini, tentunya Anda perlu memahami terlebih dahulu berbagai informasi meliputi apa itu uji E. Coli, prinsip dasar yang digunakan, hingga tahapan runtut secara lengkap di artikel ini.
Daftar Isi
Pengertian Uji E. Coli
Uji E Coli merupakan sebuah metode pengujian pada salah satu bakteri coliform secara isolasi, yaitu bakteri E.coli pada cemaran air di sekitar lingkungan.
Pengujian ini biasanya dilakukan pada ekosistem air untuk mendeteksi aktivitas bakteri E.coli secara akurat. Dengan mengetahui secara akurat konsentrasi E.coli pada suatu sampel ini, maka nantinya para penguji dapat mengetahui keseluruhan hasil pada sebuah ekosistem melalui perhitungan.
Sehingga setelah hasil uji didapatkan, para penguji dapat mengambil langkah yang tepat untuk menangani masalah kerusakan pada ekosistem air akibat kontaminasi bakteri E. Coli.
Prinsip Dasar Uji E. Coli
Pelaksanaan uji E. Coli ini dilakukan menggunakan salah satu prinsip dasar sebagai kinerja metodenya. Prinsip dasar uji E. Coli adalah dengan melibatkan Medium laktosa sebagai media pemantau terbentuknya gas dan asam.
Gas dan asam tersebut nantinya digunakan sebagai indikator adanya proses penguraian laktosa oleh bakteri E. Coli. Sehingga dari proses tersebut, penguji dapat mengetahui adanya E. Coli dengan mudah.
Selain itu. Adapun keterlibatan EMB Agar dan Endo Agar pada proses pengujian. EMB agar digunakan sebagai pendeteksi bakteri E.coli berdasarkan warna koloni dan bentuk batangnya, sementara itu Endo Agar berguna sebagai pemantau perubahan warna pada medianya.
Tahapan Uji E.coli
Uji E. Coli tentunya harus dilakukan dengan berbagai tahapan runtut guna mendapatkan hasil uji yang akurat. Berikut adalah penjelasan lengkap 3 tahapan yang diperlukan pada uji E. Coli.
Uji Pendugaan
Pada tahapan ini, para penguji akan menentukan adanya bakteri E. Coli pada suatu sampel. Yaitu dengan melakukan inkubasi sampel pada medium yang sesuai seperti laktosa dan melakukan pemantauan berkala pada tabung inkubasi tersebut.
Uji Penegasan
Jika hasil uji penduga dinilai positif terdapat bakteri E.coli dalam sampel, maka tahap selanjutnya adalah dengan memastikan kembali pengujian dengan menggunakan medium pembeda. Yaitu dengan menggunakan medium EMB agar untuk membedakan bakteri E. Coli dari bakteri lain.
Uji Lengkap
Tahap terakhir ini dilakukan untuk memastikan kembali jenis bakteri E. Coli pada sebuah sampel menggunakan Endo Agar untuk melihat perubahan warna pada sampel.
Penggunaan Uji E. Coli
Bakteri E. Coli yang berasal dari kotoran manusia dapat mencemari berbagai lingkungan, terlebih lagi pada ekosistem air. Maka dari itu, uji E. Coli bisa diterapkan pada lingkungan yang diduga tercemar tersebut guna mencegah dampak negatif yang berkelanjutan.
Selain itu, bakteri ini juga bisa mengkontaminasi makanan. Biasanya kontaminasi pada makanan ini berasal dari sumber air yang digunakan pada penanaman/ pengolahan telah tercemar. Maka dari itu sebelum menggunakan sumber air sebagai penunjang produktivitas sebuah industri makanan, penting bagi Anda untuk melakukan uji E. Coli ini.
Dimana Jasa Uji E. Coli yang Profesional dan Terpercaya?
Dengan pentingnya pelaksanaan uji E. Coli, tentunya tahap-tahap yang dilakukan haruslah memenuhi syarat laboratorium dan dilakukan oleh para ahli yang berkompeten seperti di kalibrasi.com, penyedia jasa uji E.Coli yang menjadi solusi praktis dan efektif.
Kesimpulan
Uji E.coli merupakan sebuah metode pengujian pada salah satu bakteri coliform secara isolasi, yaitu bakteri E.coli pada cemaran air di sekitar lingkungan.
Dengan melaksanakan tahapan-tahapan dengan runtut sesuai standar keamanan laboratorium dan bantuan para penguji ahli dari kalibrasi.com, sekarang tentunya cemaran air di lingkungan tersebut bisa dicegah dengan baik.